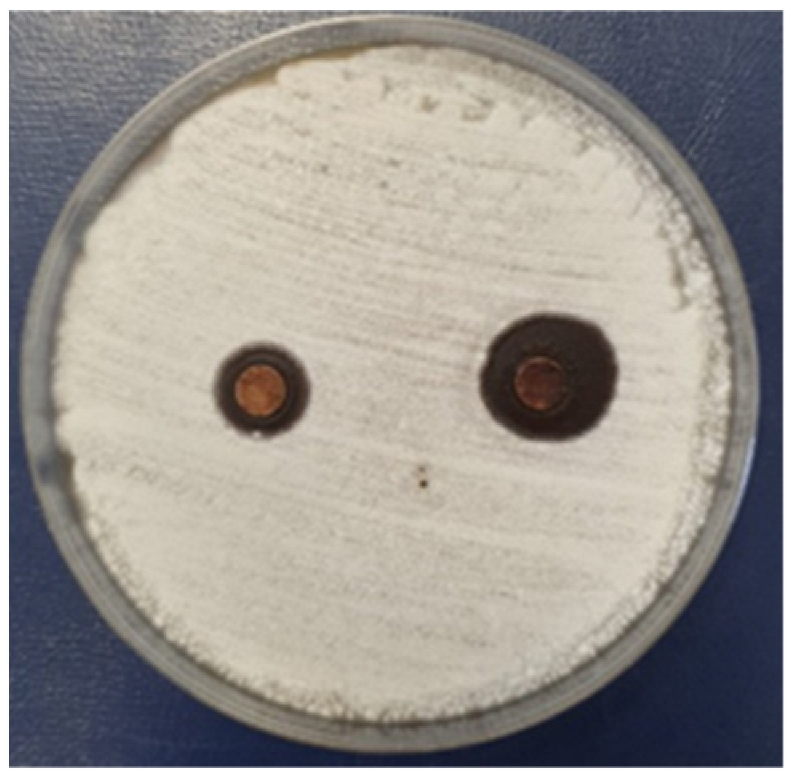
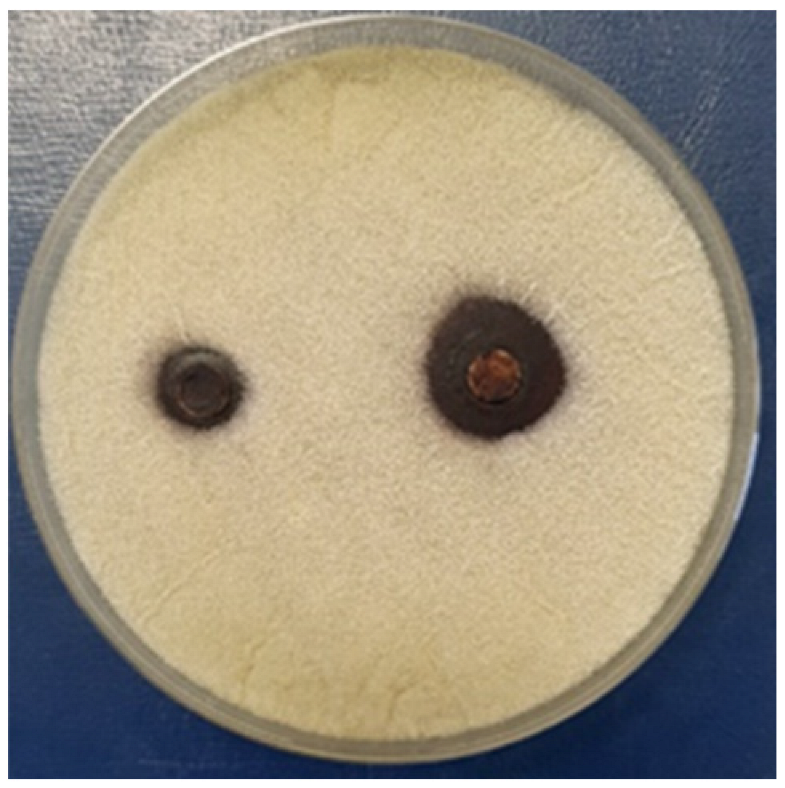
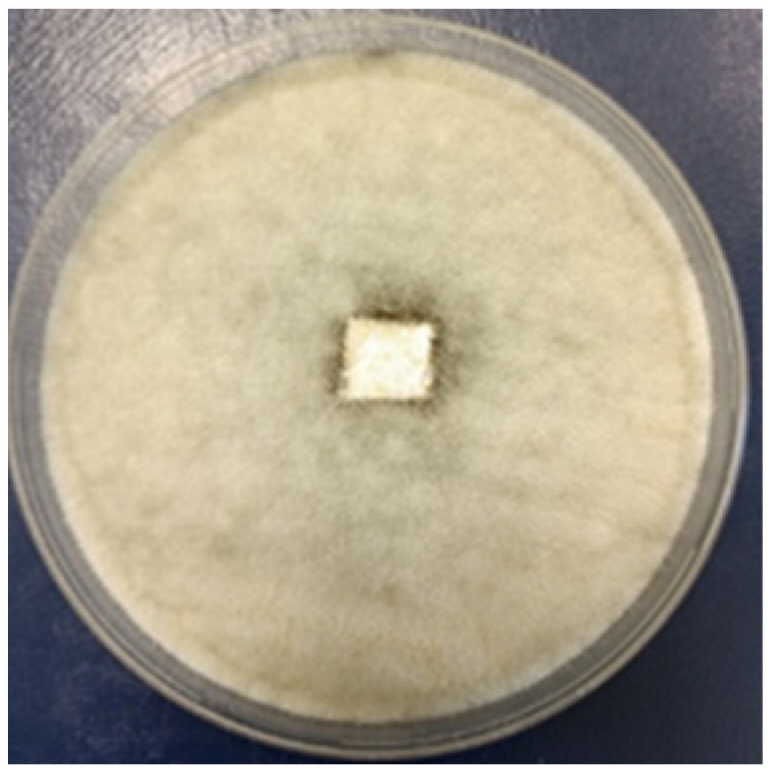
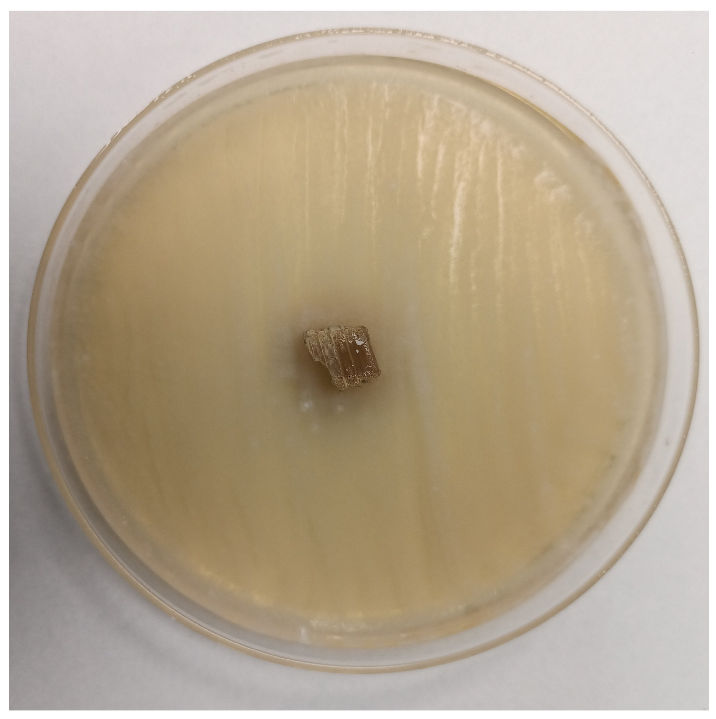
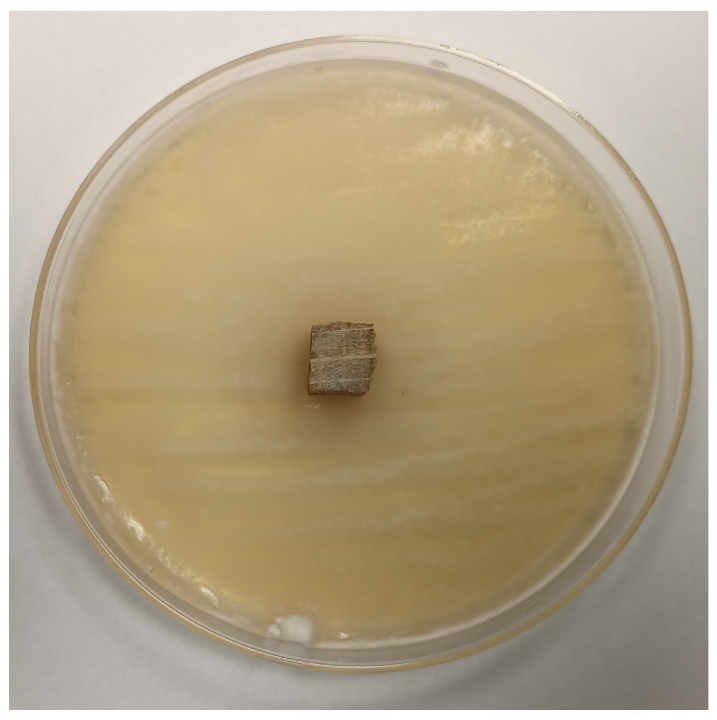
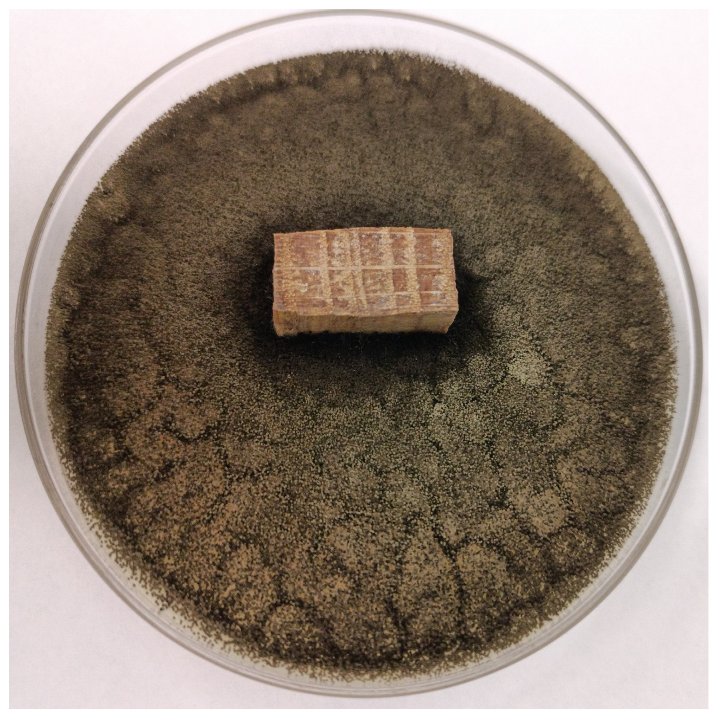

Sustainable and Functional Polymeric Coating for Wood Preservation
Abstract
1. Introduction
2. Materials and Methods
2.1. Lignin Extraction from Lignocellulosic Biomass
2.2. Lignin Decoration with ZnO Nanoparticles
2.3. Wood Specimens’ Treatment
2.4. Testing Methods
3. Results and Discussions
3.1. The Extraction and ZnO Decoration of Soda Lignin
3.2. Characterization of Coated Wood Specimens
3.2.1. The Retention of Wood Preservative
3.2.2. Aspect and Morphology of Coatings
3.2.3. Hydrophobicity
3.2.4. Antifungal Activity
3.2.5. Thermal and UV Stability of Coatings
4. Conclusions
Author Contributions
Funding
Institutional Review Board Statement
Informed Consent Statement
Data Availability Statement
Acknowledgments
Conflicts of Interest
References
- Alfieri, P.V.; Lofeudo, R.; Canosa, G. Impregnant formulation to the preservation, protection and consolidation of wood heritage assets. Int. J. Conserv. Sci. 2018, 9, 629–640. [Google Scholar]
- David, M.E.; Ion, R.-M.; Grigorescu, R.M.; Iancu, L.; Constantin, M.; Stirbescu, R.M.; Gheboianu, A.I. Wood Surface Modification with Hybrid Materials Based on Multi-Walled Carbon Nanotubes. Nanomaterials 2022, 12, 1990. [Google Scholar] [CrossRef] [PubMed]
- Teacă, C.-A.; Roşu, D.; Mustaţă, F.; Rusu, T.; Roşu, L.; Roşca, I.; Varganici, C.-D. Natural Bio-Based Products for Wood Coating and Protection against Degradation: A Review. BioResources 2019, 14, 4873–4901. [Google Scholar] [CrossRef]
- Rowell, R.M. Chemical modification of wood: A short review. Wood Mater. Sci. Eng. 2006, 1, 29–33. [Google Scholar] [CrossRef]
- Favaro, M.; Mendichi, R.; Ossola, F.; Russo, U.; Simon, S.; Tomasin, P.; Vigato, P.A. Evaluation of polymers for conservation treatments of outdoor exposed stone monuments. Part I: Photo-oxidative weathering. Polym. Degrad. Stab. 2006, 91, 3083–3096. [Google Scholar] [CrossRef]
- Salla, J.; Pandey, K.K.; Srinivas, K. Improvement of UV resistance of wood surfaces by using ZnO nanoparticles. Polym. Degrad. Stab. 2012, 97, 592–596. [Google Scholar] [CrossRef]
- Manoudis, P.N.; Karapanagiotis, I.; Tsakalof, A.; Zuburtikudis, I.; Kolinkeova, B.; Panayiotou, C. Superhydrophobic films for the protection of outdoor cultural heritage assets. Appl. Phys. A-Mater. Sci. Process. 2009, 97, 351–360. [Google Scholar] [CrossRef]
- Tuduce-Traistaru, A.-A.; Campean, M.; Timar, M.C. Compatibility indicators in developing consolidation materials with nanoparticle insertions for old wooden objects. Int. J. Conserv. Sci. 2010, 1, 219–226. [Google Scholar]
- Abbasi, J.; Samanian, K.; Afsharpor, M. Evaluation of Polvinyl butyral and zinc oxide nanocomposite for consolidation of historical woods. Int. J. Conserv. Sci. 2017, 8, 207–214. [Google Scholar]
- Khanna, S.; Srivastava, A.K. Recent advances in microbial polyhydroxyalkanoates. Process Biochem. 2005, 40, 607–619. [Google Scholar] [CrossRef]
- Bugnicourt, E.; Cinelli, P.; Alvarez, V.; Lazzeri, A. Polyhydroxyalkanoate (PHA): Review of synthesis, characteristics, processing and potential applications in packaging. Express Polym. Lett. 2014, 8, 791–808. [Google Scholar] [CrossRef]
- Chen, G.-Q. Plastics Completely Synthesized by Bacteria: Polyhydroxyalkanoates. In Plastics from Bacteria: Natural Functions and Applications; Chen, G.G.-Q., Ed.; Springer: Berlin/Heidelberg, Germany, 2010; pp. 17–37. [Google Scholar]
- Andreotti, S.; Franzoni, E.; Esposti, M.D.; Fabbri, P. Poly(hydroxyalkanoate)s-Based Hydrophobic Coatings for the Protection of Stone in Cultural Heritage. Materials 2018, 11, 165. [Google Scholar] [CrossRef] [PubMed]
- Rivera-Briso, A.L.; Serrano-Aroca, Á. Poly(3-Hydroxybutyrate-co-3-Hydroxyvalerate): Enhancement Strategies for Advanced Applications. Polymers 2018, 10, 732. [Google Scholar] [CrossRef] [PubMed]
- Lemes, A.P.; Soto-Oviedo, M.; Waldman, W.; Innocentini-Mei, L.; Durán, N. Effect of lignosulfonate on the thermal and morphological behavior of poly (3-hydroxybutyrate-co-3-hydroxyvalerate). J. Polym. Environ. 2010, 18, 250–259. [Google Scholar] [CrossRef]
- Grigore, M.E.; Grigorescu, R.M.; Iancu, L.; Ion, R.-M.; Zaharia, C.; Andrei, E.R. Methods of synthesis, properties and biomedical applications of polyhydroxyalkanoates: A review. J. Biomater. Sci. Polym. Ed. 2019, 30, 695–712. [Google Scholar] [CrossRef] [PubMed]
- Chan, C.M.; Pratt, S.; Halley, P.; Richardson, D.; Werker, A.; Laycock, B.; Vandi, L.-J. Mechanical and physical stability of polyhydroxyalkanoate (PHA)-based wood plastic composites (WPCs) under natural weathering. Polym. Test. 2019, 73, 214–221. [Google Scholar] [CrossRef]
- Hussien Ali, A.; Moghadam, P.N.; Faris, A.H.; Abdullah, M.Z. Synthesis and Characterization of Titanium Dioxide (TiO2) and Zinc Oxide (ZnO) Nanoparticles to Encapsulated Soda Lignin Polymer. J. Appl. Organomet. Chem. 2024, 4, 338–348. [Google Scholar] [CrossRef]
- Vasile, C.; Baican, M. Lignins as Promising Renewable Biopolymers and Bioactive Compounds for High-Performance Materials. Polymers 2023, 15, 3177. [Google Scholar] [CrossRef] [PubMed]
- Boarino, A.; Klok, H.A. Opportunities and Challenges for Lignin Valorization in Food Packaging, Antimicrobial, and Agricultural Applications. Biomacromolecules 2023, 24, 1065–1077. [Google Scholar] [CrossRef] [PubMed]
- Bhat, R.; Abdullah, N.; Din, R.H.; Tay, G.-S. Producing novel sago starch based food packaging films by incorporating lignin isolated from oil palm black liquor waste. J. Food Eng. 2013, 119, 707–713. [Google Scholar] [CrossRef]
- Makri, S.P.; Xanthopoulou, E.; Valera, M.A.; Mangas, A.; Marra, G.; Ruiz, V.; Koltsakidis, S.; Tzetzis, D.; Zoikis Karathanasis, A.; Deligkiozi, I.; et al. Poly(Lactic Acid) Composites with Lignin and Nanolignin Synthesized by In Situ Reactive Processing. Polymers 2023, 15, 2386. [Google Scholar] [CrossRef] [PubMed]
- Taher, M.A.; Wang, X.; Hasan, K.M.F.; Miah, M.; Zhu, J.; Chen, J. Lignin Modification for Enhanced Performance of Polymer Composites. ACS Appl. Bio Mater. 2023, 6, 5169–5192. [Google Scholar] [CrossRef] [PubMed]
- Atallah, E.; Zeaiter, J.; Ahmad, M.N.; Leahy, J.J.; Kwapinski, W. Hydrothermal carbonization of spent mushroom compost waste compared against torrefaction and pyrolysis. Fuel Process. Technol. 2021, 216, 106795. [Google Scholar] [CrossRef]
- Ma, X.; Yan, S.; Wang, M. Spent mushroom substrate: A review on present and future of green applications. J. Environ. Manag. 2025, 373, 123970. [Google Scholar] [CrossRef] [PubMed]
- Leong, Y.K.; Ma, T.-W.; Chang, J.-S.; Yang, F.-C. Recent advances and future directions on the valorization of spent mushroom substrate (SMS): A review. Bioresour. Technol. 2022, 344, 126157. [Google Scholar] [CrossRef] [PubMed]
- Rao, W.; Zhang, D.; Guan, X.; Pan, X. Recycling of spent mushroom substrate biowaste as an Anti-UV agent for Bacillus thuringiensis. Sustain. Chem. Pharm. 2022, 30, 100811. [Google Scholar] [CrossRef]
- Beckers, S.J.; Dallo, I.A.; del Campo, I.; Rosenauer, C.; Klein, K.; Wurm, F.R. From Compost to Colloids—Valorization of Spent Mushroom Substrate. ACS Sustain. Chem. Eng. 2019, 7, 6991–6998. [Google Scholar] [CrossRef]
- Adi, M.R.M.; Izhar, T.N.T.; Ibrahim, N.M.; Aziz, N.A.; Hadiyanto, H.; Matei, M. The Effect of Chemical Treated Spent Mushroom Substrate (SMS) on Lignocellulosic Content. IOP Conf. Ser. Earth Environ. Sci. 2023, 1216, 012015. [Google Scholar] [CrossRef]
- Singh, S.K.; Dhepe, P.L. Isolation of lignin by organosolv process from different varieties of rice husk: Understanding their physical and chemical properties. Bioresour. Technol. 2016, 221, 310–317. [Google Scholar] [CrossRef] [PubMed]
- Liu, M. Application of Aspergillus Niger in the resourcable utilization of straw. IOP Conf. Ser. Earth Environ. Sci. 2021, 859, 012092. [Google Scholar] [CrossRef]
- Karuppan Perumal, M.K.; Rajasekaran, M.B.S.; Rajan Renuka, R.; Samrot, A.V.; Nagarajan, M. Zinc oxide nanoparticles and their nanocomposites as an imperative coating for smart food packaging. Appl. Food Res. 2025, 5, 100849. [Google Scholar] [CrossRef]
- Mohd Yusof, H.; Mohamad, R.; Zaidan, U.H.; Abdul Rahman, N.A. Microbial synthesis of zinc oxide nanoparticles and their potential application as an antimicrobial agent and a feed supplement in animal industry: A review. J. Anim. Sci. Biotechnol. 2019, 10, 57. [Google Scholar] [CrossRef] [PubMed]
- Cuadra, J.G.; Scalschi, L.; Vicedo, B.; Guc, M.; Izquierdo-Roca, V.; Porcar, S.; Fraga, D.; Carda, J.B. ZnO/Ag Nanocomposites with Enhanced Antimicrobial Activity. Appl. Sci. 2022, 12, 5023. [Google Scholar] [CrossRef]
- Zhou, X.-Q.; Hayat, Z.; Zhang, D.-D.; Li, M.-Y.; Hu, S.; Wu, Q.; Cao, Y.-F.; Yuan, Y. Zinc Oxide Nanoparticles: Synthesis, Characterization, Modification, and Applications in Food and Agriculture. Processes 2023, 11, 1193. [Google Scholar] [CrossRef]
- Zhang, Z.; Terrasson, V.; Guénin, E. Lignin Nanoparticles and Their Nanocomposites. Nanomaterials 2021, 11, 1336. [Google Scholar] [CrossRef] [PubMed]
- Tang, Q.; Qian, Y.; Yang, D.; Qiu, X.; Qin, Y.; Zhou, M. Lignin-Based Nanoparticles: A Review on Their Preparations and Applications. Polymers 2020, 12, 2471. [Google Scholar] [CrossRef] [PubMed]
- Kirar, S.; Mohne, D.; Singh, M.; Sagar, V.; Bhise, A.; Goswami, S.; Bhaumik, J. Eco-friendly lignin nanocomposite films as advanced UV protective and antimicrobial sustainable packaging materials. Sustain. Mater. Technol. 2024, 40, e00864. [Google Scholar] [CrossRef]
- Tuduce Trǎistaru, A.-A.; Crina Anca Sandu, I.; Cristina Timar, M.; Lucia Dumitrescu, G.; Sandu, I. SEM-EDX, water absorption, and wetting capability studies on evaluation of the influence of nano-zinc oxide as additive to paraloid B72 solutions used for wooden artifacts consolidation. Microsc. Res. Tech. 2013, 76, 209–218. [Google Scholar] [CrossRef] [PubMed]
- ASTM D2244; Standard Practice for Calculation of Color Tolerances and Color Differences from Instrumentally Measured Color Coordinates. ASTM International: West Conshohocken, PA, USA, 2013.
- Aurélien, S.; Daniel, S. Drop Shape Analysis. Available online: https://bigwww.epfl.ch/demo/dropanalysis/ (accessed on 14 April 2025).
- Horikawa, Y.; Hirano, S.; Mihashi, A.; Kobayashi, Y.; Zhai, S.; Sugiyama, J. Prediction of Lignin Contents from Infrared Spectroscopy: Chemical Digestion and Lignin/Biomass Ratios of Cryptomeria japonica. Appl. Biochem. Biotechnol. 2019, 188, 1066–1076. [Google Scholar] [CrossRef] [PubMed]
- Ab Rahim, A.H.; Man, Z.; Sarwono, A.; Wan Hamzah, W.; Mohamad Yunus, N.; Wilfred, C. Extraction and Comparative Analysis of Lignin Extract from Alkali and Ionic Liquid Pretreatment. J. Phys. Conf. Ser. 2018, 1123, 012052. [Google Scholar] [CrossRef]
- Akpakpan, A.; Edu, J.; Ita, B.; Akpabio, U. Physicochemical Properties of Soda and Kraft Lignin Extracted from Gmelina arborea Wood. Int. Res. J. Pure Appl. Chem. 2023, 24, 9–19. [Google Scholar] [CrossRef]
- Wang, H.; Qiu, X.; Liu, W.; Fu, F.; Yang, D. A Novel Lignin/ZnO Hybrid Nanocomposite with Excellent UV-Absorption Ability and Its Application in Transparent Polyurethane Coating. Ind. Eng. Chem. Res. 2017, 56, 11133–11141. [Google Scholar] [CrossRef]
- Zhang, L.; Wang, Y.; Yang, D.; Wang, H.; Liu, W.; Li, Z. Multilayer two-dimensional lignin/ZnO composites with excellent anti-UV aging properties for polymer films. Green Chem. Eng. 2022, 3, 338–348. [Google Scholar] [CrossRef]
- Yue, X.; Suopajärvi, T.; Sun, S.; Mankinen, O.; Mikkelson, A.; Huttunen, H.; Komulainen, S.; Romakkaniemi, I.; Ahola, J.; Telkki, V.-V.; et al. High-purity lignin fractions and nanospheres rich in phenolic hydroxyl and carboxyl groups isolated with alkaline deep eutectic solvent from wheat straw. Bioresour. Technol. 2022, 360, 127570. [Google Scholar] [CrossRef] [PubMed]
- Jose, L.M.; Kuriakose, S.; Thomas, S. Fabrication, Characterization and In Vitro Antifungal Property Evaluation of Biocompatible Lignin-Stabilized Zinc Oxide Nanoparticles Against Selected Pathogenic Fungal Strains. BioNanoScience 2020, 10, 583–596. [Google Scholar] [CrossRef]
- Aiduang, W.; Jatuwong, K.; Kiatsiriroat, T.; Kamopas, W.; Tiyayon, P.; Jawana, R.; Xayyavong, O.; Lumyong, S. Spent Mushroom Substrate-Derived Biochar and Its Applications in Modern Agricultural Systems: An Extensive Overview. Life 2025, 15, 317. [Google Scholar] [CrossRef] [PubMed]
- Jordan, S.N.; Mullen, G.J.; Murphy, M.C. Composition variability of spent mushroom compost in Ireland. Bioresour. Technol. 2008, 99, 411–418. [Google Scholar] [CrossRef] [PubMed]
- Del Buono, D.; Luzi, F.; Tolisano, C.; Puglia, D.; Di Michele, A. Synthesis of a Lignin/Zinc Oxide Hybrid Nanoparticles System and Its Application by Nano-Priming in Maize. Nanomaterials 2022, 12, 568. [Google Scholar] [CrossRef] [PubMed]
- Bhuiyan, M.; Mamur, H. A Brief Review of the Synthesis of ZnO Nanoparticles for Biomedical Applications. Iran. J. Mater. Sci. Eng. 2021, 18, 1–27. [Google Scholar] [CrossRef]
- Hosseini, S.A.; Babaei, S. Graphene Oxide/Zinc Oxide (GO/ZnO) Nanocomposite as a Superior Photocatalyst for Degradation of Methylene Blue (MB)-Process Modeling by Response Surface Methodology (RSM). J. Braz. Chem. Soc. 2016, 28, 299–307. [Google Scholar] [CrossRef]
- Naseer, H.; Al-Zaqri, N.; Iqbal, T.; Yousaf, M.; Afsheen, S.; Sultan, M.S.; Warad, I.; Farooq, M.; Masood, A. Investigation of Mg Doped ZnO Nanoparticles Decorated with Ag for Efficient Photocatalytic Degradation. J. Inorg. Organomet. Polym. Mater. 2023, 33, 2790–2802. [Google Scholar] [CrossRef]
- Shichao, W.; Hengxue, X.; Renlin, W.; Zhe, Z.; Meifang, Z. Influence of amorphous alkaline lignin on the crystallization behavior and thermal properties of bacterial polyester. J. Appl. Polym. Sci. 2015, 132, 41325. [Google Scholar] [CrossRef]
- Adjaoud, A.; Dieden, R.; Verge, P. Sustainable Esterification of a Soda Lignin with Phloretic Acid. Polymers 2021, 13, 637. [Google Scholar] [CrossRef] [PubMed]
- Iancu, L.; Grigorescu, R.M.; Ion, R.-M.; David, M.E.; Slamnoiu-Teodorescu, S. The Effect of UV Irradiation on the Stability of Coated Fir Wood Samples. Sci. Bull. ‘Valahia’ Univ. Mater. Mech. 2022, 18, 8–14. [Google Scholar] [CrossRef]
- Dvořák, O.; Kvietková, M.S.; Šimůnková, K.; Machanec, O.; Pánek, M.; Pastierovič, F.; Lin, C.-F.; Jones, D. The Influence of the Initial Treatment of Oak Wood on Increasing the Durability of Exterior Transparent Coating Systems. Polymers 2023, 15, 3251. [Google Scholar] [CrossRef] [PubMed]
- Hui, Z.; Haonan, Z.; Hao, R.; Huamin, Z. Optimized preparation of spruce kraft lignin/ZnO composites and their performance analysis in polyurethane films. Int. J. Biol. Macromol. 2022, 209, 1465–1476. [Google Scholar] [CrossRef] [PubMed]
- Zare, M.; Keerthiraj, D.N.; Ilyas, S.; Hezam, A.; Mathur, D.S.; Byrappa, K. Smart Fortified PHBV-CS Biopolymer with ZnO−Ag Nanocomposites for Enhanced Shelf Life of Food Packaging. ACS Appl. Mater. Interfaces 2019, 11, 48309–48320. [Google Scholar] [CrossRef] [PubMed]
- Pasquet, J.; Chevalier, Y.; Pelletier, J.; Couval, E.; Bouvier, D.; Bolzinger, M.-A. The contribution of zinc ions to the antimicrobial activity of zinc oxide. Colloids Surf. A Physicochem. Eng. Asp. 2014, 457, 263–274. [Google Scholar] [CrossRef]
- Vargas Hernández, R.; Alvarez Lemus, M.A.; De la Rosa García, S.; López González, R.; Quintana, P.; García Zaleta, D.; Velázquez Vázquez, V.; Gómez Cornelio, S. Antifungal Activity of ZnO Nanoparticles Synthesized from Eichhornia crassipes Extract for Construction Applications. Nanomaterials 2024, 14, 1007. [Google Scholar] [CrossRef] [PubMed]
- Vitasovic, T.; Caniglia, G.; Eghtesadi, N.; Ceccato, M.; Jesen, E.; Gosewinkel, U.; Neusser, G.; Rupp, U.; Walther, P.; Kranz, C.; et al. Antibacterial Action of Zn2+ Ions Driven by the In Vivo Formed ZnO Nanoparticles. ACS Appl. Mater. Interfaces 2024, 16, 30847–30859. [Google Scholar] [CrossRef] [PubMed]
- Nada, A.; El-Diwany, A.; Elshafei, A. Infrared and antimicrobial studies on different lignins. Acta Biotechnol. 1989, 9, 295–298. [Google Scholar] [CrossRef]
- Sunthornvarabhas, J.; Liengprayoon, S.; Suwonsichon, T. Antimicrobial kinetic activities of lignin from sugarcane bagasse for textile product. Ind. Crops Prod. 2017, 109, 857–861. [Google Scholar] [CrossRef]
- Reyes, D.C.; Ma, Z.; Romero, J.J. The Antimicrobial Properties of Technical Lignins and Their Derivatives—A Review. Polymers 2024, 16, 2181. [Google Scholar] [CrossRef] [PubMed]
- Lebow, S.T. Wood preservation. In Wood Handbook: Wood as an Engineering Material, Centennial ed.; General technical report FPL.; GTR-190; Chapter 15; US Department of Agriculture, Forest Service, Forest Products Laboratory: Madison, WI, USA, 2010; Volume 190, pp. 15.1–15.28. [Google Scholar]
- Food and Agriculture Organization of the United Nations Mechanical Wood Products Branch. Wood Preservation Manual; Food and Agriculture Organization of the United Nations: Rome, Italy, 1986. [Google Scholar]
- Erazo, A.; Mosquera, S.A.; Rodríguez-Paéz, J.E. Synthesis of ZnO nanoparticles with different morphology: Study of their antifungal effect on strains of Aspergillus niger and Botrytis cinerea. Mater. Chem. Phys. 2019, 234, 172–184. [Google Scholar] [CrossRef]
- Ardiansyah, R.; Santoso, I. The effect of zinc oxide nanoparticles against ceiling mold isolate. IOP Conf. Ser. Earth Environ. Sci. 2020, 481, 012017. [Google Scholar] [CrossRef]
- Öner, M.; Kılıç, B.; Sudurağı, M.; Abamor, E.Ş.; Akgül, B.; Üner, B.K. Development of hybrid bionanocomposites of poly (3-hydroxybutyrate-co-3-hydroxyvalerate) with zinc oxide and silicon-doped hydroxyapatite nanocrystals and machine learning for predicting dynamic mechanical properties. Int. J. Biol. Macromol. 2025, 294, 139338. [Google Scholar] [CrossRef] [PubMed]
- Camargo, F.A.; Innocentini-Mei, L.H.; Lemes, A.P.; Moraes, S.G.; Durán, N. Processing and characterization of composites of poly (3-hydroxybutyrate-co-hydroxyvalerate) and lignin from sugar cane bagasse. J. Compos. Mater. 2012, 46, 417–425. [Google Scholar] [CrossRef]
- Müller, U.; Rätzsch, M.; Schwanninger, M.; Steiner, M.; Zöbl, H. Yellowing and IR-changes of spruce wood as result of UV-irradiation. J. Photochem. Photobiol. B Biol. 2003, 69, 97–105. [Google Scholar] [CrossRef] [PubMed]
- Kúdela, J.; Ihracký, P.; Kačík, F. Discoloration and Surface Changes in Spruce Wood after Accelerated Aging. Polymers 2024, 16, 1191. [Google Scholar] [CrossRef] [PubMed]
- Allegretti, O.; Travan, L.; Cividini, R. Drying techniques to obtain white beech. In Proceedings of the Wood EDG Conference, Bled, Slovenia, 23 April 2009; pp. 7–13. [Google Scholar]
- Palija, T.; Dobić, J.; Jaić, M. A photochemical method for improvement of color stability at polymer–wood biointerfaces. Colloids Surf. B Biointerfaces 2013, 108, 152–157. [Google Scholar] [CrossRef] [PubMed]
- Geffertová, J.; Geffert, A.; Výbohová, E. The effect of UV irradiation on the colour change of the spruce wood. Acta Fac. Xylologiae Zvolen Res Publica Slovaca 2018, 60, 41–50. [Google Scholar]
- Cogulet, A.; Blanchet, P.; Landry, V. Wood degradation under UV irradiation: A lignin characterization. J. Photochem. Photobiol. B Biol. 2016, 158, 184–191. [Google Scholar] [CrossRef] [PubMed]
- Wei, L.; McDonald, A.G. Accelerated weathering studies on the bioplastic, poly (3-hydroxybutyrate-co-3-hydroxyvalerate). Polym. Degrad. Stab. 2016, 126, 93–100. [Google Scholar] [CrossRef]












| Raman Shift (cm−1) | Assignment |
|---|---|
| 223 | Skeletal vibration of polysaccharides |
| 394 | C-C skeletal bending in cellulose |
| 423 | Additional skeletal bending in cellulose and hemicellulose |
| 442 | C-C and C-O stretching of polysaccharides |
| 490 | Aromatic ring deformation in lignin |
| 565 | C-O stretching in cellulose and hemicellulose |
| 584 | C-H bending in lignin |
| 1086 | C-O-C stretching in cellulose and hemicellulose |
| 1323 | C-H bending in lignin (syryngyl and guaiacyl units) |
| 1591 | Aromatic ring stretching (lignin marker) |
| 1860 | Conjugated C=O groups (degradation products) |
| Sample | Control Wood | Wood-PHBHV | Wood-PHBHV.L | Wood-PHBHV.LZnO | |
|---|---|---|---|---|---|
| Aspect | ![]() | ![]() | ![]() | ![]() | |
| SEM morphology | ![]() | ![]() | ![]() | ![]() | |
| Preservative retention, % | - | 1.232 ± 0.18 | 1.244 ± 0.08 | 1.274 ± 0.002 | |
| Chromatic parameters | Lx* | 81.830 | 78.290 | 78.385 | 77.840 |
| ax* | 2.560 | 3.300 | 3.273 | 3.113 | |
| bx* | 4.920 | 4.235 | 3.590 | 3.835 | |
| Water absorption, % | 67.627 | 45.734 | 41.750 | 34.624 | |
| Humidity, % | 34.911 | 6.192 | 8.431 | 4.734 | |
| L | L.ZnO | L | L.ZnO | ||
|---|---|---|---|---|---|
| Spot Inoculation | Disk Inoculation | ||||
| Penicillium chrysogenum | |||||
![]() | ![]() | ![]() | ![]() | ||
| Aspergillus niger | |||||
| - | ![]() | - | ![]() | ||
| PHBHV film | PHBHV.L film | PHBHV.LZnO film | |||
| Penicillium chrysogenum | |||||
![]() | ![]() | ![]() | |||
| Aspergillus niger | |||||
![]() | ![]() | ![]() | |||
| Time | Control wood | Wood–PHBHV | Wood–PHBHV.L | Wood–PHBHV.LZnO |
|---|---|---|---|---|
| Penicillium chrysogenum | ||||
| 24 h | ![]() | ![]() | ![]() | ![]() |
| 72 h | ![]() | ![]() | ![]() | ![]() |
| Aspergillus niger | ||||
| 24 h | ![]() | ![]() | ![]() | ![]() |
| 72 h | ![]() | ![]() | ![]() | ![]() |
Disclaimer/Publisher’s Note: The statements, opinions and data contained in all publications are solely those of the individual author(s) and contributor(s) and not of MDPI and/or the editor(s). MDPI and/or the editor(s) disclaim responsibility for any injury to people or property resulting from any ideas, methods, instructions or products referred to in the content. |
© 2025 by the authors. Licensee MDPI, Basel, Switzerland. This article is an open access article distributed under the terms and conditions of the Creative Commons Attribution (CC BY) license (https://creativecommons.org/licenses/by/4.0/).
Share and Cite
Grigorescu, R.M.; Ion, R.-M.; Iancu, L.; Slamnoiu-Teodorescu, S.; Gheboianu, A.I.; Alexandrescu, E.; David, M.E.; Constantin, M.; Raut, I.; Damian, C.M.; et al. Sustainable and Functional Polymeric Coating for Wood Preservation. Coatings 2025, 15, 875. https://doi.org/10.3390/coatings15080875
Grigorescu RM, Ion R-M, Iancu L, Slamnoiu-Teodorescu S, Gheboianu AI, Alexandrescu E, David ME, Constantin M, Raut I, Damian CM, et al. Sustainable and Functional Polymeric Coating for Wood Preservation. Coatings. 2025; 15(8):875. https://doi.org/10.3390/coatings15080875
Chicago/Turabian StyleGrigorescu, Ramona Marina, Rodica-Mariana Ion, Lorena Iancu, Sofia Slamnoiu-Teodorescu, Anca Irina Gheboianu, Elvira Alexandrescu, Madalina Elena David, Mariana Constantin, Iuliana Raut, Celina Maria Damian, and et al. 2025. "Sustainable and Functional Polymeric Coating for Wood Preservation" Coatings 15, no. 8: 875. https://doi.org/10.3390/coatings15080875
APA StyleGrigorescu, R. M., Ion, R.-M., Iancu, L., Slamnoiu-Teodorescu, S., Gheboianu, A. I., Alexandrescu, E., David, M. E., Constantin, M., Raut, I., Damian, C. M., Nicolae, C.-A., & Trica, B. (2025). Sustainable and Functional Polymeric Coating for Wood Preservation. Coatings, 15(8), 875. https://doi.org/10.3390/coatings15080875